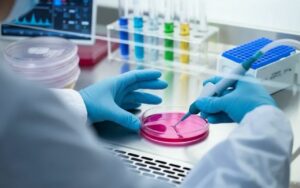

ИНФОРМАЦИЯ О ПЕРЕСАДКЕ
СТВОЛОВЫХ КЛЕТОК В ЮЖНОЙ КОРЕЕ
Трансплантация гемопоэтических стволовых клеток — это забор недифференцированных клеток у здорового человека и их введение путем инъекции пациенту с серьезными заболеваниями крови. Лечение стволовыми клетками в Корее активно применяется при наличии у больного онкогематологических заболеваний — лейкоз, множественная миелома, остеосаркома и другие.
Трансплантация гемопоэтических стволовых клеток — это забор недифференцированных клеток у здорового человека и их введение путем инъекции пациенту с серьезными заболеваниями крови. Лечение стволовыми клетками в Корее активно применяется при наличии у больного онкогематологических заболеваний — лейкоз, множественная миелома, остеосаркома и другие.
Пересадка стволовых клеток в Кореевозможна от донора со схожим набором антиген или самого пациента и занимает не более 2-х часов. Госпиталь Сеульского Национального Университета (SNUH) показывает выдающиеся результаты по трансплантации гемопоэтических стволовых клеток с 50-ти процентной совместимостью. Выживаемость — 85%, а у пациентов с лейкемией и злокачественными заболеваниями — 82% успешных операций.
ПОДГОТОВКА К ТРАНСПЛАНТАЦИИ
Перед процедурой назначают ударную химиотерапию. Чем больше доза вводимых химиопрепаратов, тем эффективнее проходит лечение раковых клеток. Она в 4-6 раз выше стандартной дозировки. Также высокая доза химиотерапии может совмещаться с биотерапией. При этом истребляются клетки злокачественной опухоли вместе с «родными» стволовыми. После уже проводится пересадка.







